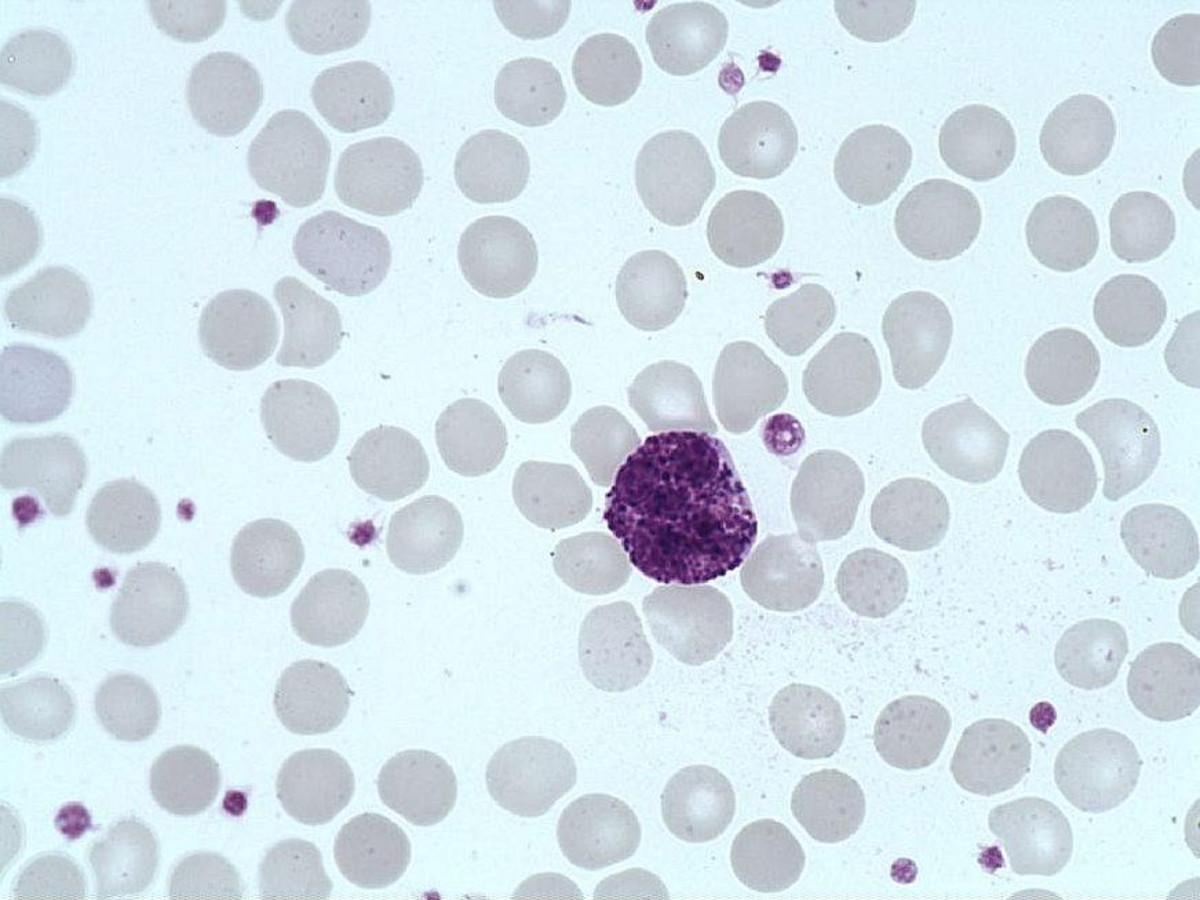
Basophil_polymorphonuclear

Basophil polymorphonuclear
- Size : Medium, 12-15 µm
- N/C ratio= Medium, 0.4
- Cytoplasm
- Extension : Abundant
- Basophilia : Absent
- Number of granules : Numerous
- Color of granules : Black- dark violet = basophil
- Membrane : Regular
- Nucleus
- Situation : Eccentric
- Chromatin : Dense
- Nucleoli : Absent
- Membrane : Regular
- Normal values : <0.2 x 10(-9)/L
- Description / Pathology :
Round cell of average size, bilobed nucleus with condensed chromatin, no nucleolus, unstained cytoplasm covered by large very irregular basophilic granules.
Excess of basophils in Chronic Myeloid Leukemia.